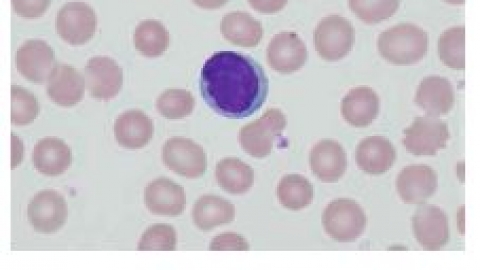

白细胞减少症的治疗方法都有哪些
白细胞减少症指外周血液中白细胞计数持续碳酸锂可增加粒细胞的生成,但对慢性骨髓功能衰竭者无效。G-CSF对周期性粒细胞减少和严重的先天性粒细胞缺乏儿童效果较好,它能加速化疗引起白细胞减少的恢复,亦可用于预防强烈化疗引起的白细胞减少和发热。在骨髓衰竭为粒细胞缺乏的原发病因,并排除了免疫介导所致的症状严重者可考虑异基因造血干...
05-14
白细胞旧称白血球。血液中的一类细胞。颗粒白细胞(粒细胞)中含
白细胞旧称白血球。血液中的一类细胞。颗粒白细胞(粒细胞)中含有特殊染色颗粒,用瑞氏染料染色可分辨出三种颗粒白细胞即嗜中性粒细胞、嗜酸性粒细胞和嗜碱性粒细胞;无颗粒白细胞包括单核细胞和淋巴细胞。各类白细胞的防御保护作用各不相同。T淋巴细胞主要参与细胞免疫反应而B淋巴细胞参与体液免疫反应。正常人每立方毫米的血液时白细胞为止...
05-12

人体的卫士——白细胞
而淋巴细胞主要参与机体的免疫应答反应,一般情况下,淋巴细胞的寿命较长,它们往返于血液、组织液、淋巴液之间,而且可以在淋巴结等处增殖分化,展示出它们强大的抵御能力。白细胞抗击病毒的这一过程,与其具有变形、游走、趋化、吞噬和分泌等特性息息相关。此外,白细胞还可分泌多种细胞因子,如白细胞介素、干扰素、肿瘤坏死因子、集落刺激因...
05-11

白细胞_药学_医药卫生_专业资料
1.10.尿毒症、糖尿病酮症酸中毒以及有机磷农药、催眠药等化学药的急性中毒。2.只要出现白血病既可以选择白细胞增多也可以选择白细胞减少。3.4.、白血病、自身免疫性疾病等。杆菌感染寄生虫感染——疟疾。伤肿瘤细胞的同时,杀伤正常细胞)等。4.中毒等。甲状腺)也可引起减少。5.0.50~0.0.20~0.感染白细胞和中性粒...
05-11

白细胞_临床医学_医药卫生_专业资料
白细胞根据形态差异可分为颗粒和无颗粒两大类。这类白细胞也具有吞噬功能。①限制嗜碱性粒细胞在速发性过敏反应中的作用。在对蠕虫的免疫反应中,嗜酸性粒细胞有重要的作用。简介这类细胞的颗粒内含有组织胺、肝素和过敏性慢反应物质等。嗜碱性颗粒的特点与肥大细胞的颗粒相似,但两种细胞的关系尚待研究。血液中主要是小淋巴细胞和一定数量的中...
05-10

白细胞俗称白血球,是血液中重要的细胞成分,包括中性粒细胞、嗜
白细胞俗称白血球,是血液中重要的细胞成分,包括中性粒细胞、嗜酸性粒细胞、嗜碱性粒细胞、淋巴细胞、单核细胞和肥大细胞等。感染:急性感染尤其是细菌(如金黄色葡萄球菌、肺炎链球菌等)感染,白细胞总数增多,而某些急性重症感染白细胞总数反而降低;部分病原微生物感染如疟疾、黑热病等,也可引起白细胞数增多伴单核细胞增多。
05-10

白细胞减少症的危害都有哪些,我们该如何预防
这就要从预防感染说起,下面就让治疗血液病医院的专家为大家讲解一下,白细胞减少症的危害都有哪些。人体和动物血液及组织中的无色细胞。不同生理状态(如妊娠期)会引起白细胞数量的变化。有炎症时,血中的白细胞数明显增加。白细胞减少症如何预防与护理1、白细胞减少症患者应注意休息,因为过度疲劳容易使病程缠绵难愈,甚至使病情加重。对传...
05-10
-
共1页 7条

